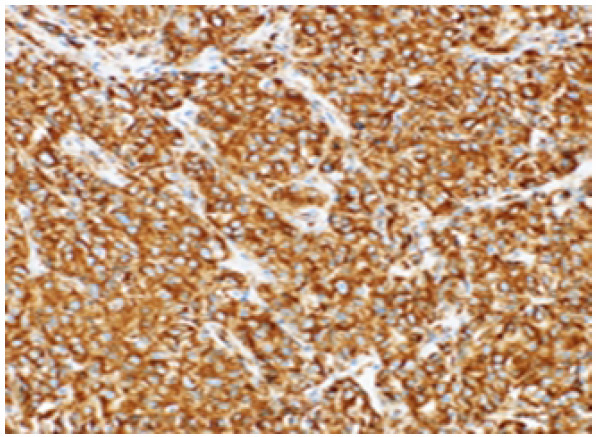

Abstract
Introduction
Osseous angiosarcoma is a very rare tumor of bone with aggressive behavior, propensity for recurrences, and distant metastasis. The etiology of osseous angiosarcoma is uncertain; however, specific risk factors have been recognized. The diagnosis of angiosarcoma of bone demands multimodality imaging in conjunction with histopathological and vascular marker evaluation to aptly differentiate them from other vascular tumors. Treatment of osseous angiosarcoma remains controversial.
Case Report
A 53-year-old male presented with pain and swelling of the right upper 1/3rd of the arm following heaviness while lifting weight for 3 months. He had a history of significant weight loss and appetite with no history of inciting trauma or irradiation in the past. On examination, a diffuse swelling was noted in the right shoulder and right scapular aspect with varied consistency and ill-defined borders and margins. The skin over the swelling was stretched and shiny with dilated engorged veins over it. The plain radiograph of the right shoulder with humerus revealed a large expansile lytic soft-tissue mass in the right proximal humerus with a wide zone of transition without sclerotic margins. Magnetic resonance imaging showed T1 hypointense, T2/PDFS hyperintense large well-defined expansile lytic lesion with multi-loculated cysts, and multiple blood-fluid levels involving right proximal humerus. The patient underwent an incisional biopsy which exhibited angiosarcoma of the humerus. The patient was treated with six cycles of chemotherapy with a mesna, doxorubicin, ifosfamide, and dacarbazine regimen. The patient was still under follow-up.
Conclusion
Being a rare clinical entity, controversy exists in angiosarcoma of humerus regarding its etiology and recommended management protocols. Histopathology and immunohistochemistry remain the gold standard in differentiating osseous angiosarcoma from other osseous vascular tumors. The treatment protocol has to be standardized to decrease morbidity and to improve the functional quality of life of the patient.
Keywords: Angiosarcoma, humerus, chemotherapy
Learning Point of the Article:
Being a rare vascular sarcoma of osseous origin, the article illustrates the various histopathological and immunohistochemical examination findings that aid in the diagnosis of the condition and also highlights the appropriate management of the tumour.
Introduction
Primary angiosarcoma of bone is an extremely rare neoplasm of mesenchymal origin. The tumor biology exhibits an aggressive natural course with rapid malignant transformation and marked anaplasia .[1] Osseous angiosarcoma has a propensity for recurrences and distant metastasis. At a glance, about 6% of all angiosarcomas develop in the bone [2, 3]. The etiology of osseous angiosarcoma is uncertain;, however, specific risk factors have been recognized .[4]. The diagnosis of angiosarcoma of bone demands multimodality imaging in conjunction with histopathological and vascular marker evaluation to aptly differentiate them from hemangioma, metastatic carcinoma, renal cell carcinoma, and bacillary angiomatosis [5, 6, –7]. However, treatment is quite challenging and involves multi-modality management options such as chemotherapy, neoadjuvant chemotherapy, surgical resection, and radiotherapy [3, 8]. Here, in this article, we report a case of angiosarcoma of the humerus bone in a 53-year-old male and provide a review of the literature on the same account to outline the importance of clinico-radio-histological assessment of the patient for prompt diagnosis and management of such deceptive neoplasm.
Case Report
A 53-year-old man came with pain and swelling of the right upper third arm following heaviness while lifting weight for 3 months. The pain was sudden in onset, dull aching, radiating to the scapular aspect without any aggravating or relieving factors. The swelling appeared to be a lemon-sized one which gradually progressed in the last past 3 months. The patient had associated paraesthesia, numbness, and restricted mobility of the shoulder. The patient reported a history of significant weight loss and appetite. There was no history of inciting trauma or irradiation in the past. On examination, a diffuse swelling was noted in the right shoulder and right scapular aspect measuring approximately 15 cm ×x 10 cm ×x 7 cms. Swelling showed varied consistency with ill-defined borders & and margins. The skin over the swelling was stretched and shiny with dilated engorged veins over it. No bruit was felt over the swelling.
The metabolic profile revealed a 10ten-fold rise in serum alkaline phosphatase and significant elevation of lactate dehydrogenase. Plain radiograph of the right shoulder with humerus revealed a large expansile lytic soft- tissue mass in the right proximal humerus involving both cortex and medulla with a wide zone of transition without sclerotic margins (as shown in Fig. 1a, 1b). Non-enhanced computed tomography (CT) NECT scan of the right shoulder (coronal and axial sections) revealed a large expansile lytic soft- tissue density mass lesion measuring 10.8 cm × 7.8 cm × 9.2 cms at right upper 1/3rd of the humerus and showing loss of fat planes with right subscapularis, supraspinatus, and abutting right deltoid and pectoralis major muscle (as shown in Fig. 2a, 2b). Magnetic resonance imaging (MRI) showed T1 hypointense, T2/PDFS hyperintense large well defined expansile lytic lesion measuring 10.8 cm × 7.9 cm × 9.2 cms with multi-loculated cysts and multiple blood-fluid levels involving right proximal humerus infiltrating right subscapularis and supraspinatus muscle with hyperintensities in infraspinatus and teres minor muscles (as shown in Fig. 3a- to 3e). Tc-99m methylene diphosphonate (MDP) bone scan revealed abnormal tracer uptake in the right upper 1/3rd of humerus and scapula. No metastatic lesions were demonstrated with fluorine-18-fluorodeoxyglucose positron emission tomography (PET) imaging.
Figure 1.

(a) Anterioposterior and (b) (lateral): Plain radiograph of chest with bilateral shoulder showing single large homogenously opaque lytic lesion in the proximal metadiaphyseal region of right shoulder without any periosteal reaction.
Figure 2.

(a) (coronal) and (b) (axial): Computed tomography of right shoulder showing heterogenous soft-tissue lesion in metadiaphyseal region of right shoulder with multiple low attenuating cytic areas within it. The lesion is seen closely abutting deltoid muscle.
Figure 3.

Magnetic resonance imaging of right shoulder: (a) Coronal T1-weighed image showing heterogeneously hypointense lesion with few areas of hyperintense hemorrhages, (b) coronal T1 contrast enhanced image showing heterogenous enhancement within the lesion and (c) (sagittal T2), (d) (coronal T2), and (e) (axial T2) showing heterogeneously hyperintense lesion with multiple fluid-fluid levels noted within it.
The radiological evidence with the clustering of multifocal lesions in a single anatomic region throws a high index of suspicion towards osseous vascular tumors. It is highly questionable to differentiate between angiosarcoma, hemangioendothelioma, and hemangiopericytoma. Angiosarcoma may be more destructive, but cellular differentiation is not reliable. The possible differential diagnosis was bone marrow metastases, multiple myeloma, osseous angiosarcoma, osseous hemangioendothelioma, and osseous hemangiopericytoma.
With the suspicion of a malignant tumor, the patient was subjected to an incisional biopsy. Grossly, the tumourigenic tissue was friable, tan red, and hemorrhagic with few areas of necrosis. Histopathologically, the tumor showed cytologically malignant cells that were epithelioid in appearance. The nuclei were vesicular and contain one or two small nucleoli and occasional macronuclei. The cytoplasm was scant to moderate, deeply eosinophilic, hold intact, and fragmented erythrocytes. Areas of vasoformation were also seen along with numerous mitotic figures. The tumor cells were arranged in solid sheets and also line the irregular vascular lumina. Along with extravasated erythrocytes scattered deposits of hemosiderin were present. A variable inflammatory infiltrates consisting of lymphocytes and neutrophils were also seen (as shown in Fig. 4).
Figure 4.

Histopathological examination showing epitheloid cells with vesicular nucleus, one or two small nucleoli and occasional macronucleoli. Areas of vasoformation along with numerous mitotic figures and irregular vascular lumina were visualized.
Immunohistochemical analysis demonstrated von Willebrand factor, Vimentin, CD-31 (as shown in Fig. 5) and -34, factor 8 RA positivity which confirmed the tumor of vascular origin, and hence a confirmed diagnosis of primary angiosarcoma of osseous origin (humerus) was made.
Figure 5.
Immunohistochemistry examination showing strongly positive for CD31.
Our patient was treated with 6 cycles (one cycle per /month) of palliative chemotherapeutic agents according to mesna, doxorubicin, ifosfamide, and dacarbazine (MAID) protocol (mesna, doxorubicin, ifosfamide, and dacarbazine) and was followed up for 6 months after the last cycle of chemotherapy. The patient presented with a decreased in the size of the mass with decreased pain over the right humerus at the end of 1 year. The patient was still under follow-up.
Discussion
Angiosarcomas are very rare, high-grade malignant tumors with a spectrum comprising hemangiomas, hemangioendotheliomas, well or poorly differentiated angiosarcomas [9]. The cell of origin in angiosarcoma is endothelial cell either vascular or lymphatic origin. It represents 1% of all soft- tissue sarcomas [5]. Angiosarcoma occurs most predominantly in the cutaneous region followed by deep tissues such as the liver, breast, bone, and spleen [5]. They exhibit hematogenous spread with the lungs being the most common site for metastasis, followed by the liver, bones, soft tissues, and lymph nodes. The pathological diagnosis of angiosarcoma depends on the grading of tumorigenic cells either of high or low grade [10]. The overall survival rate ranges from 6 to 16 months [5]. The prognosis depends on the local recurrence and distant metastasis.
The knowledge of osseous angiosarcoma on its biology and behavior are is meager in the literature because of its very rare occurrence. Osseous angiosarcoma accounts for less than <1% of all primary malignant bone tumors with the worst prognosis [3]. Angiosarcoma of bone has slight male preponderance (M:F – 2:1) with affection towards 3rd third to 5th fifth decades of life [3, 5, 11]. Most commonly it occurs in tubular long bones (60%) [(tibia [(23%)], femur [(18%)], and humerus [(13%])]), followed by axial skeleton (40%) [6]. Osseous angiosarcoma can be divided into primary being idiopathic and secondary being due to prior irradiation, lymphoedema, Paget’’s disease of bone, and bony infarction [12, 13]. The two most commonly reported symptoms are pain and swelling at the local site. Vermaat et al. stated that up to 30% of malignant vascular tumors are multifocal [14]. Humeral primary angiosarcoma is a very rare tumorigenic entity and the review of the published such cases have beenare tabulated in (Table 1).
Table 1.
Literature review for angiosarcoma humerus
On conventional radiography, osseous angiosarcoma exhibits variable presentations of the lytic lesion with cortical destruction, without sclerosis. Tumors show osseous expansile and eccentric lesions without a periosteal reaction. An expansile bony lesion is observed in low-grade osseous angiosarcoma whereas cortical permeation, a geographical lytic lesion with soft- tissue infiltrations is observed in high-grade aggressive osseous angiosarcoma. Angiosarcoma of bone rarely shows calcifications. Lv et al. explained the aggressiveness of angiosarcoma in the lower extremity as an osteolytic destructive lesion with an ill-defined cortico-medullary junction [1]. In our case, a large expansile lytic soft- tissue mass in the right proximal humerus involving both cortex and medulla with a wide zone of transition without sclerotic margins was observed.
CT stands superior in evaluating the bony destruction than conventional radiographs. CT serves as a useful diagnostic tool in terms of sensitivity for lesion detection and provides a precise anatomic extent of the disease [20]. MRI is considered as the gold standard diagnostic modality in demonstrating the invasiveness of bone and soft- tissue components and assists in the staging of the tumor. MRI offers tissue characterization [4]. Lv et al. observed mottled, the increased signal on T1- weighted MRI. They observed enhanced MRI demonstrated the infiltration level of the lesion [1]. Griffith et al. observed hypointensity in T1W images within the humerus where it contains numerous serpiginous vascular channels. These vascular channels demonstrated fluid-filled levels on T2W images. On administration of contrast medium, the lesion exhibited a heterogeneous enhancement into soft- tissue component [21]. Our case showed hypointensity on T1W images and hyperintensity on T2W/PDFS images with large well-defined expansile lytic lesion with multi-loculated cysts and multiple blood-fluid levels involving right proximal humerus infiltrating right subscapularis and supraspinatus muscle with hyperintensities in infraspinatus and teres minor muscles. Osseous scintigraphy with 99mTC MDP show increased uptake by the tumor cells and helps in assessing the multifocality of the tumor [22] .
Osseous angiosarcoma must be differentiated from osseous haemangiopericytoma and osseous haemangioendothelioma [23]. Hence, tissue diagnosis and immunohistochemistry are essential to confirm the diagnosis. The differential diagnosis for osseous angiosarcoma is tabulated in (Table 2). Angiosarcomas typically have ill-defined margins and exhibit a considerable degree of cellular atypia and architectural differentiation. They range from well-formed, anastomosing vessels to solid sheets of high-grade epithelioid or spindled cells without clear vasoformation. Most of the tumors show high-grade morphology with anastomosing vascular channels or more solid areas, variable nuclear atypia, mitotic activity, and coagulative necrosis. Sometimes atypia is mild and focal with cells resembling normal vascular endothelium. Marked pleomorphism is rare. Vasoformative areas are composed of ramifying channels lined by the atypical spindle or epithelioid cells, with variable endothelial multilayering, intraluminal budding, hobnailing, or papillary-like projections. The vascular channels may be poorly formed with complex dissecting patterns. Solid areas typically comprise cellular sheets of spindled to epithelioid cells with abundant eosinophilic to amphophilic cytoplasm, large vesicular nuclei, and prominent nucleoli. These may be associated with blood lakes or extensive hemorrhage and organizing hematoma. More rarely tumors appear morphologically low grade with well-formed vascular channels lined by minimally atypical spindled cells. Epitheloid angiosarcomas typically have a solid architecture, with diffuse, sheet-like patterns of large, atypical epithelioid or polygonal cells with ovoid vesicular nuclei, prominent large central nucleoli, and abundant cytoplasm [23, 24, –25]. The difference between histological variants of osseous angiosarcoma were is tabulated in (Table 3) [26]. Immunohistochemistry confirms the diagnosis of angiosarcoma with positivity for endothelial cell surface markers (CD31, CD34, factor 8 RA, Ulex europaeus agglutinin I, FLI-I, and thrombomodulin), epithelial markers (cytokeratins & and epithelial membrane antigen) Vimentin, and von Willebrand factor [27, 28].
Table 2.
Differential diagnosis of angiosarcoma on basis of histopathology
Table 3.
Difference between histological variants of osseous angiosarcoma

(Table 2): Differential diagnosis of angiosarcoma on basis of histopathology
Due to the rarity of the tumor, the management options are yet to be explored. No specific treatment options for osseous angiosarcoma have been mentioned in the available literature. Yamashita et al. recommended that surgical modality coupled with immediate post-operative radiotherapy prove to be a viable treatment option for cases where complete resection is possible [7]. Various researchers have investigated multiple combinations of chemotherapeutic agents like such ass cisplatin + doxorubicin, cisplatin + paclitaxel, and cisplatin + doxorubicin + paclitaxel [29, 30, –31]. With the existing plausible literature, it has been understood that angiosarcoma responds well with a chemotherapeutic agent like anthracycline. Baliaka et al. treated primary angiosarcoma of the proximal femur with a dose of 300 cGy per fraction in 13 days followed by replacement with custom-made total hip arthroplasty [32]. With the available treatment options, we have given 6 six cycles of MAID regimen without any surgical modality as our case does not show any metastatic lesions in PET-CT. For metastatic lesions, palliative therapy of chemotherapeutic agents with radiotherapy is advocated.
Prognostic factors include patient age, tumor grade (risk assessment based on histopathologic characteristics), tumor depth (superficial or deep), tumor size, histological subtype, surgical margin status at resection, and disease status (primary or recurrent disease). Due to the aggressive behavior of angiosarcoma, the five5-year survival rate was 33% [33]. Verbeke et al. described the distinct histological features of primary angiosarcoma of bone which were defined by malignant spectrum (mitotic figures and nuclear atypia) of osseous vascular tumors. The worst prognostic markers were more than 3 mitoses per /10 HPF, the presence of a macronucleus, and the presence of fewer than five 5 eosinophils per /10 HPF. With all these histopathological features in the osseous angiosarcoma, the 5-year survival rate is 0%. D2-40 marker lymphangiogenic differentiation displays the more aggressive behavior of the tumor [33]. Our case was still under our follow-up.
Conclusion
Being a rare clinical entity, controversy exists in angiosarcoma of humerus regarding its etiology and recommended management protocols. Histopathology and immunohisto-chemistry remain the gold standard in differentiating osseous angiosarcoma from other osseous vascular tumors. The treatment protocol has to be standardized to decrease morbidity and to improve the functional quality of life of the patient.
Clinical Message.
Being a rare vascular sarcoma of osseous origin, histopathology, and immunohistochemistry examination aids in diagnosis and its appropriate management of the tumor.
Biography
Footnotes
Conflict of Interest: Nil
Source of Support: Nil
Consent: The authors confirm that informed consent was obtained from the patient for publication of this case report
References
- 1.Lv L, Xu P, Shi Y, Hao J, Hu C, Zhao B. Imaging features of soft tissue epithelioid angiosarcoma in the lower extremity:A case report. Oncol Lett. 2016;11:3457–60. doi: 10.3892/ol.2016.4407. [DOI] [PMC free article] [PubMed] [Google Scholar]
- 2.Goldblum JR, Folpe AL, Weiss SW. Enzinger and Weiss's Soft Tissue Tumors. 6th Philadelphia, PA: Saunders/Elsevier; c2014. [Last accessed on 2021 Mar 19]. Available from: https://www.elsevier.com/ books/enzinger-and-weisss-soft-tissue-tumors/ goldblum/ 978-0-323-08834-3 . [Google Scholar]
- 3.Palmerini E, Maki RG, Staals EL, Alberghini M, Antonescu CR, Ferrari C, et al. Primary angiosarcoma of bone:A retrospective analysis of 60 patients from two institutions. Am J Clin Oncol. 2014;37:528–34. doi: 10.1097/COC.0b013e31827defa1. [DOI] [PMC free article] [PubMed] [Google Scholar]
- 4.Cao J, Wang J, He C, Fang M. Angiosarcoma:A review of diagnosis and current treatment. Am J Cancer Res. 2019;9:2303–13. [PMC free article] [PubMed] [Google Scholar]
- 5.Gaballah AH, Jensen CT, Palmquist S, Pickhardt PJ, Duran A, Broering G, et al. Angiosarcoma:Clinical and imaging features from head to toe. Br J Radiol. 2017;90:20170039. doi: 10.1259/bjr.20170039. [DOI] [PMC free article] [PubMed] [Google Scholar]
- 6.Murphey MD, Fairbairn KJ, Parman LM, Baxter KG, Parsa MB, Smith WS. From the archives of the AFIP. Musculoskeletal angiomatous lesions:Radiologic-pathologic correlation. Radiographics. 1995;15:893–917. doi: 10.1148/radiographics.15.4.7569134. [DOI] [PubMed] [Google Scholar]
- 7.Yamashita H, Endo K, Teshima R. Angiosarcoma of the proximal humerus:A case report and review of the literature. J Med Case Reports. 2012;6:347. doi: 10.1186/1752-1947-6-347. [DOI] [PMC free article] [PubMed] [Google Scholar]
- 8.Palmerini E, Leithner A, Windhager R, Gosheger G, Boye K, Laitinen M, et al. Angiosarcoma of bone:A retrospective study of the European musculoskeletal oncology society (EMSOS) Sci Rep. 2020;10:10853. doi: 10.1038/s41598-020-66579-5. [DOI] [PMC free article] [PubMed] [Google Scholar]
- 9.Antonescu C. Malignant vascular tumors--an update. Mod Pathol. 2014;27(Suppl 1):S30–8. doi: 10.1038/modpathol.2013.176. [DOI] [PubMed] [Google Scholar]
- 10.Nathenson MJ, Molavi D, Aboulafia A. Angiosarcoma arising in a patient with a 10-year-old hemangioma. Case Rep Oncol Med. 2014;2014:185323. doi: 10.1155/2014/185323. [DOI] [PMC free article] [PubMed] [Google Scholar]
- 11.Palmerini E, Righi A, Staals EL. Rare primary malignant bone sarcomas. Cancers. 2020;12:3092. doi: 10.3390/cancers12113092. [DOI] [PMC free article] [PubMed] [Google Scholar]
- 12.Bernardo AD, Sciancalepore F, Giardina FL, Spinelli MS, Lo Duca MG, Daolio PA, et al. Angiosarcoma secondary to a Paget's disease:A rare clinical case with 5 years of follow-up and review of the literature. Case Rep Ser Surg. 2020;2020:1–4. [Google Scholar]
- 13.Tse LF, Ek ET, Slavin JL, Schlicht SM, Choong PF. Intraosseous angiosarcoma with secondary aneurysmal bone cysts presenting as an elusive diagnostic challenge. Int Semin Surg Oncol. 2008;5:10. doi: 10.1186/1477-7800-5-10. [DOI] [PMC free article] [PubMed] [Google Scholar]
- 14.Vermaat M, Vanel D, Kroon HM, Verbeke SL, Alberghini M, Bovee JV, et al. Vascular tumors of bone:Imaging findings. Eur J Radiol. 2011;77:13–8. doi: 10.1016/j.ejrad.2010.06.052. [DOI] [PubMed] [Google Scholar]
- 15.Chen KT. Hemangiosarcoma complicating Paget's disease of the bone. J Surg Oncol. 1985;28:187–9. doi: 10.1002/jso.2930280308. [DOI] [PubMed] [Google Scholar]
- 16.Hasegawa T, Fujii Y, Seki K, Yang P, Hirose T, Matsuzaki K, et al. Epithelioid angiosarcoma of bone. Hum Pathol. 1997;28:985–9. doi: 10.1016/s0046-8177(97)90016-2. [DOI] [PubMed] [Google Scholar]
- 17.Fukuroku J, Kusuzaki K, Murata H, Nakamura S, Takeshita H, Hirata M, et al. Two cases of secondary angiosarcoma arising from fibrous dysplasia. Anticancer Res. 1999;19:4451–7. [PubMed] [Google Scholar]
- 18.Voggenreiter G, Assenmacher S, Schmit-Neuerburg KP. Tikhoff-Linberg procedure for bone and soft tissue tumors of the shoulder girdle. Arch Surg. 1999;134:252–7. doi: 10.1001/archsurg.134.3.252. [DOI] [PubMed] [Google Scholar]
- 19.Mittal S, Goswami C, Kanoria N, Bhattacharya A. Post-irradiation angiosarcoma of bone. J Cancer Res Ther. 2007;3:96–9. doi: 10.4103/0973-1482.34687. [DOI] [PubMed] [Google Scholar]
- 20.Wenger DE, Wold LE. Malignant vascular lesions of bone:Radiologic and pathologic features. Skeletal Radiol. 2000;29:619–31. doi: 10.1007/s002560000261. [DOI] [PubMed] [Google Scholar]
- 21.Griffith B, Yadam S, Mayer T, Mott M, van Holsbeeck M. Angiosarcoma of the humerus presenting with fluid-fluid levels on MRI:A unique imaging presentation. Skeletal Radiol. 2013;42:1611–6. doi: 10.1007/s00256-013-1656-x. [DOI] [PubMed] [Google Scholar]
- 22.Lomasney LM, Martinez S, Demos TC, Harrelson JM. Multifocal vascular lesions of bone:Imaging characteristics. Skeletal Radiol. 1996;25:255–61. doi: 10.1007/s002560050075. [DOI] [PubMed] [Google Scholar]
- 23.Evans HL, Raymond AK, Ayala AG. Vascular tumors of bone:A study of 17 cases other than ordinary hemangioma, with an evaluation of the relationship of hemangioendothelioma of bone to epithelioid hemangioma, epithelioid hemangioendothelioma, and high-grade angiosarcoma. Hum Pathol. 2003;34:680–9. doi: 10.1016/s0046-8177(03)00249-1. [DOI] [PubMed] [Google Scholar]
- 24.Wang L, Lao IW, Yu L, Wang J. Clinicopathological features and prognostic factors in angiosarcoma:A retrospective analysis of 200 patients from a single Chinese medical institute. Oncol Lett. 2017;14:5370–8. doi: 10.3892/ol.2017.6892. [DOI] [PMC free article] [PubMed] [Google Scholar]
- 25.Abraham JA, Hornicek FJ, Kaufman AM, Harmon DC, Springfield DS, Raskin KA, et al. Treatment and outcome of 82 patients with angiosarcoma. Ann Surg Oncol. 2007;14:1953–67. doi: 10.1245/s10434-006-9335-y. [DOI] [PubMed] [Google Scholar]
- 26.Lucas DR. Angiosarcoma, radiation-associated angiosarcoma, and atypical vascular lesion. Arch Pathol Lab Med. 2009;133:1804–9. doi: 10.5858/133.11.1804. [DOI] [PubMed] [Google Scholar]
- 27.Yang Z, Tao H, Ye Z, Yang D. Multicentric epithelioid angiosarcoma of bone. Orthopedics. 2012;35:e1293–6. doi: 10.3928/01477447-20120725-39. [DOI] [PubMed] [Google Scholar]
- 28.Balicki D, Buhrmann R, Maclean J, et al. Multicentric epithelioid angiosarcoma of the bone. Pitfalls in clinical and morphological diagnosis. Blood Cells Mol Dis. 1996;22(3):205–213. doi: 10.1006/bcmd.1996.0101. doi:10.1006/bcmd.1996.0101. [DOI] [PubMed] [Google Scholar]
- 29.O'Connor MI, Sim FH, Chao EY. Limb salvage for neoplasms of the shoulder girdle. Intermediate reconstructive and functional results. J Bone Joint Surg Am. 1996;78:1872–88. doi: 10.2106/00004623-199612000-00011. [DOI] [PubMed] [Google Scholar]
- 30.Young RJ, Natukunda A, Litière S, Woll PJ, Wardelmann E, van der Graaf WT. First-line anthracycline-based chemotherapy for angiosarcoma and other soft tissue sarcoma subtypes:Pooled analysis of eleven European organisation for research and treatment of cancer soft tissue and bone sarcoma group trials. Eur J Cancer. 2014;50:3178–86. doi: 10.1016/j.ejca.2014.10.004. [DOI] [PubMed] [Google Scholar]
- 31.Budd GT. Management of angiosarcoma. Curr Oncol Rep. 2002;4:515–9. doi: 10.1007/s11912-002-0066-3. [DOI] [PubMed] [Google Scholar]
- 32.Baliaka A, Balis G, Michalopoulou-Manoloutsiou E, Papanikolaou A, Nikolaidou A. Primary angiosarcoma of bone. A case report. Hippokratia. 2013;17:180–2. [PMC free article] [PubMed] [Google Scholar]
- 33.Verbeke SL, Bertoni F, Bacchini P, Sciot R, Fletcher CD, Kroon HM, et al. Distinct histological features characterize primary angiosarcoma of bone. Histopathology. 2011;58:254–64. doi: 10.1111/j.1365-2559.2011.03750.x. [DOI] [PubMed] [Google Scholar]


